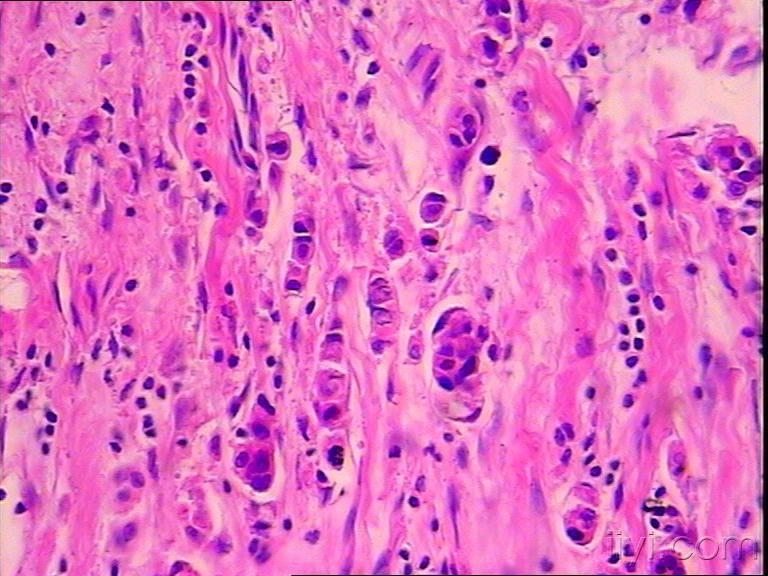
20101123女28岁右乳腺肿物

良性肿瘤切面颜色

病理学实验部分肿瘤切片
图片尺寸1080x775
行手术切除,巨检如图:肿瘤直径3cm,包膜完整,切面灰红色,部分区可见
图片尺寸700x1214
(图为巨块型肝癌切面,来自达特茅斯医学院病理科arief suriawinata)
图片尺寸800x604
肿瘤切面
图片尺寸2666x2000
成涎细胞瘤:肿瘤大体标本成多结节样,切面灰白色(罗海燕分切,摄影)
图片尺寸1268x834
题外话:甲状腺hürthle细胞肿瘤的大体切面呈红褐色,比较有特点,有
图片尺寸900x742
皮脂腺瘤:肿瘤界限清楚,切面浅黄色
图片尺寸780x799
肾脏肿瘤,女54,3x2×1,界清,切面灰白暗红
图片尺寸4160x3120
肾上腺良性肿瘤病理图谱
图片尺寸573x431
良性病变行腺叶切除术后病理证实为分化型甲状腺癌者,若切缘阴性,对侧
图片尺寸720x509
有图有真相图解7种常见肝脏肿瘤良性篇
图片尺寸900x606
大小1.8*1*1cm,切面灰白质中.
图片尺寸4032x3024
肿瘤颜色可因充血,出血,瘤体内脂肪和脂褐素含量不同而变化
图片尺寸575x428
20101123女28岁右乳腺肿物
图片尺寸768x576
平滑肌瘤或纤维瘤,是一种良性平滑肌肿瘤
图片尺寸1200x800
切开的海绵状血管瘤,切面呈海绵状
图片尺寸1097x886
肝局灶性结节性增生(fnh)位居肝脏原发良性肿瘤发病率第二,女性发病占
图片尺寸397x257
浆液性囊腺纤维瘤切面,散在可见囊内乳头状突起(箭头所示)
图片尺寸407x308
切面有黄褐色区和灰白色区
图片尺寸575x434
肝脏良性肿瘤肝腺瘤
图片尺寸720x485